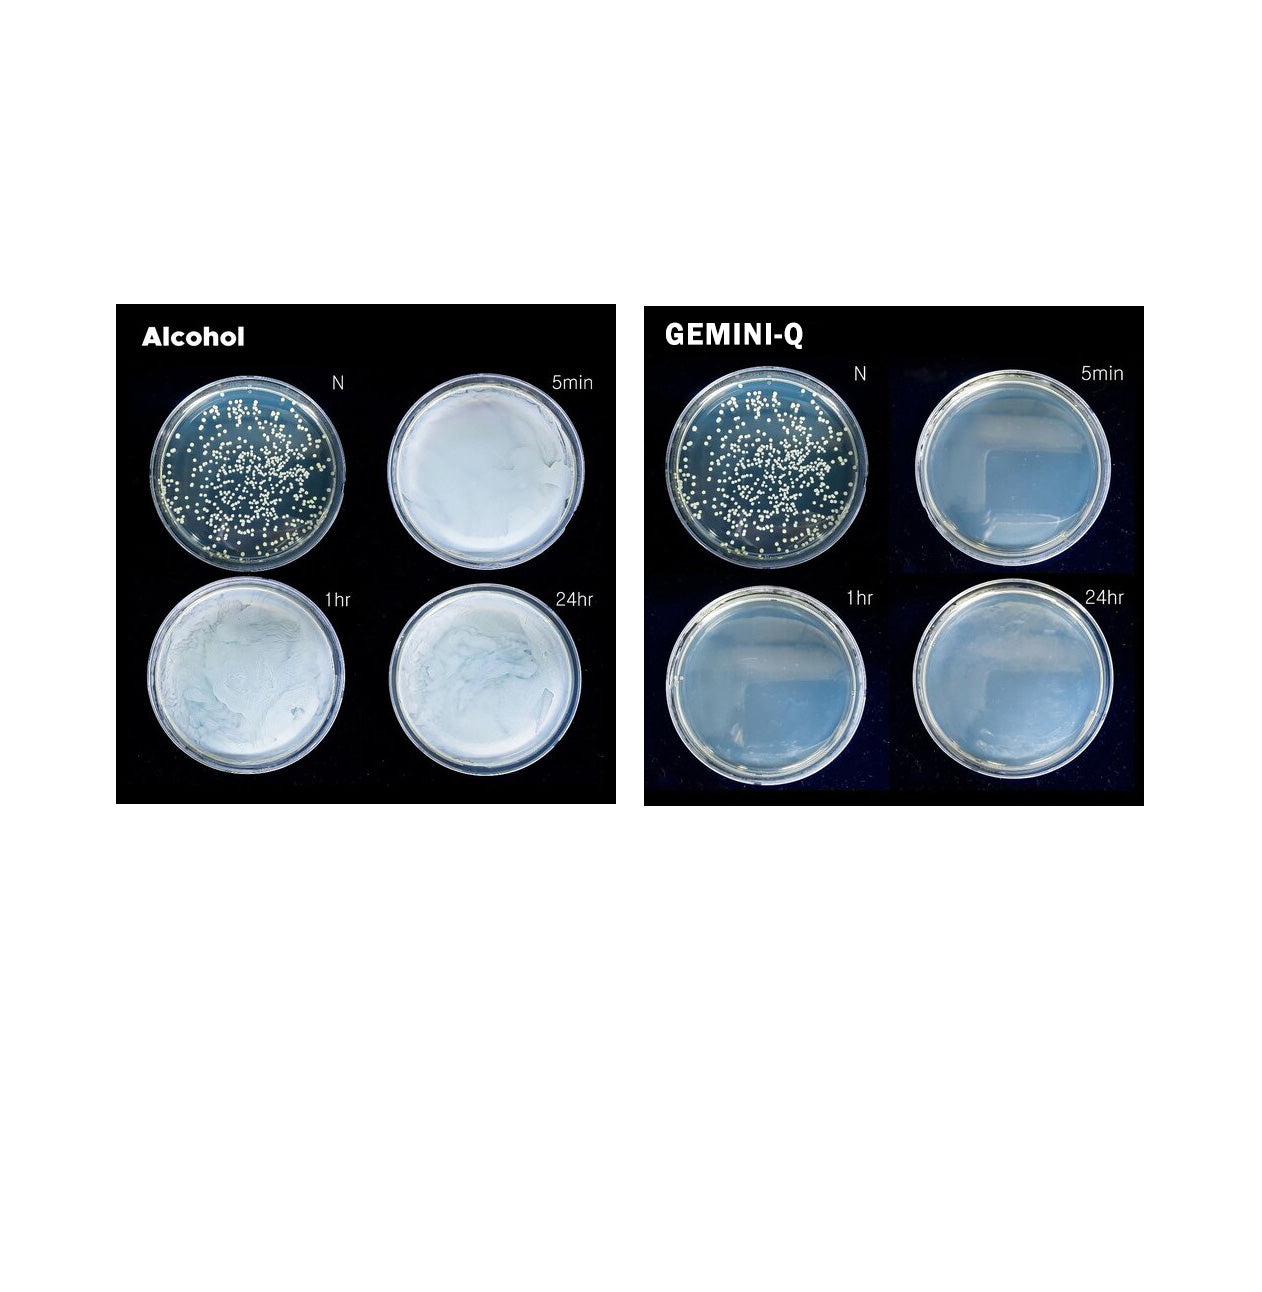

After testing various bacteria in alcohol and Gemini Q solution for 24 hours, it was found that Gemini Q has better sterilizing power than alcohol.
Zero Skin Trouble with cutting edge biomedical science
Cutting edge science
Our research team has developed a new ‘GEMINI-Q' technology to form a SELF-SANITIZING surface for inactivating and preventing BACTERIA, VIRUSES, and FUNGI that cause skin problems such as acne, melasma, and warts.
FOUNDER
Ph.D. Kollbe Ando Ahn
"Non-toxic, self-sanitizing gemini technology protects skins between washes."

Chief Scientific Officer
Ph.D. Roscoe Linstadt
Our mission is to provide hand-crafted healthier skin foods to people’s skincare routines.

Scientists Develop New ‘Gemini-Q' Technology to Form Self-Sanitizing Surfaces for Inactivating & Preventing Bacteria, Viruses, Fungi that Cause Skin Problems such as Acne.
Biomimetic Self-Cleaning for Zero Skin Problems
A new solution for many skin problems and infections has been developed by scientists from the University of California and ACatechol, Inc. (USA). This study shows that the new class of "Gemini-Q" technology inactivates problem causing bacteria, such as Cutibacterium acnes, and pathogens immediately on contact, while continuing to remain active on skin in-between cleanings, with 100 million times higher residual efficacy than currently available products. This innovative scientific research has been published in the prestigious Langmuir (a peer-reviewed journal published by the American Chemical Society) and highlighted on the cover page of the journal. “Thanks to the National Science Foundation (NSF) and National Institute of Health (NIH) for research supports, in this project, we developed a new class of quaternary ammonium coatings mediated with structural elements of powerful Gemini surfactants,” said Dr. Roscoe Linstadt, co-lead author of the study.
“This technology can eliminate skin problem-causing bacteria, viruses and fungi. More importantly, it can save more than 11 million lives each year from sepsis, the #1 cause of hospital deaths. Those healthcare-acquired infections are transmitted through skins and surfaces,” said Dr. Kollbe, corresponding author of the study.
Gemini-Q compounds are already registered with the FDA.